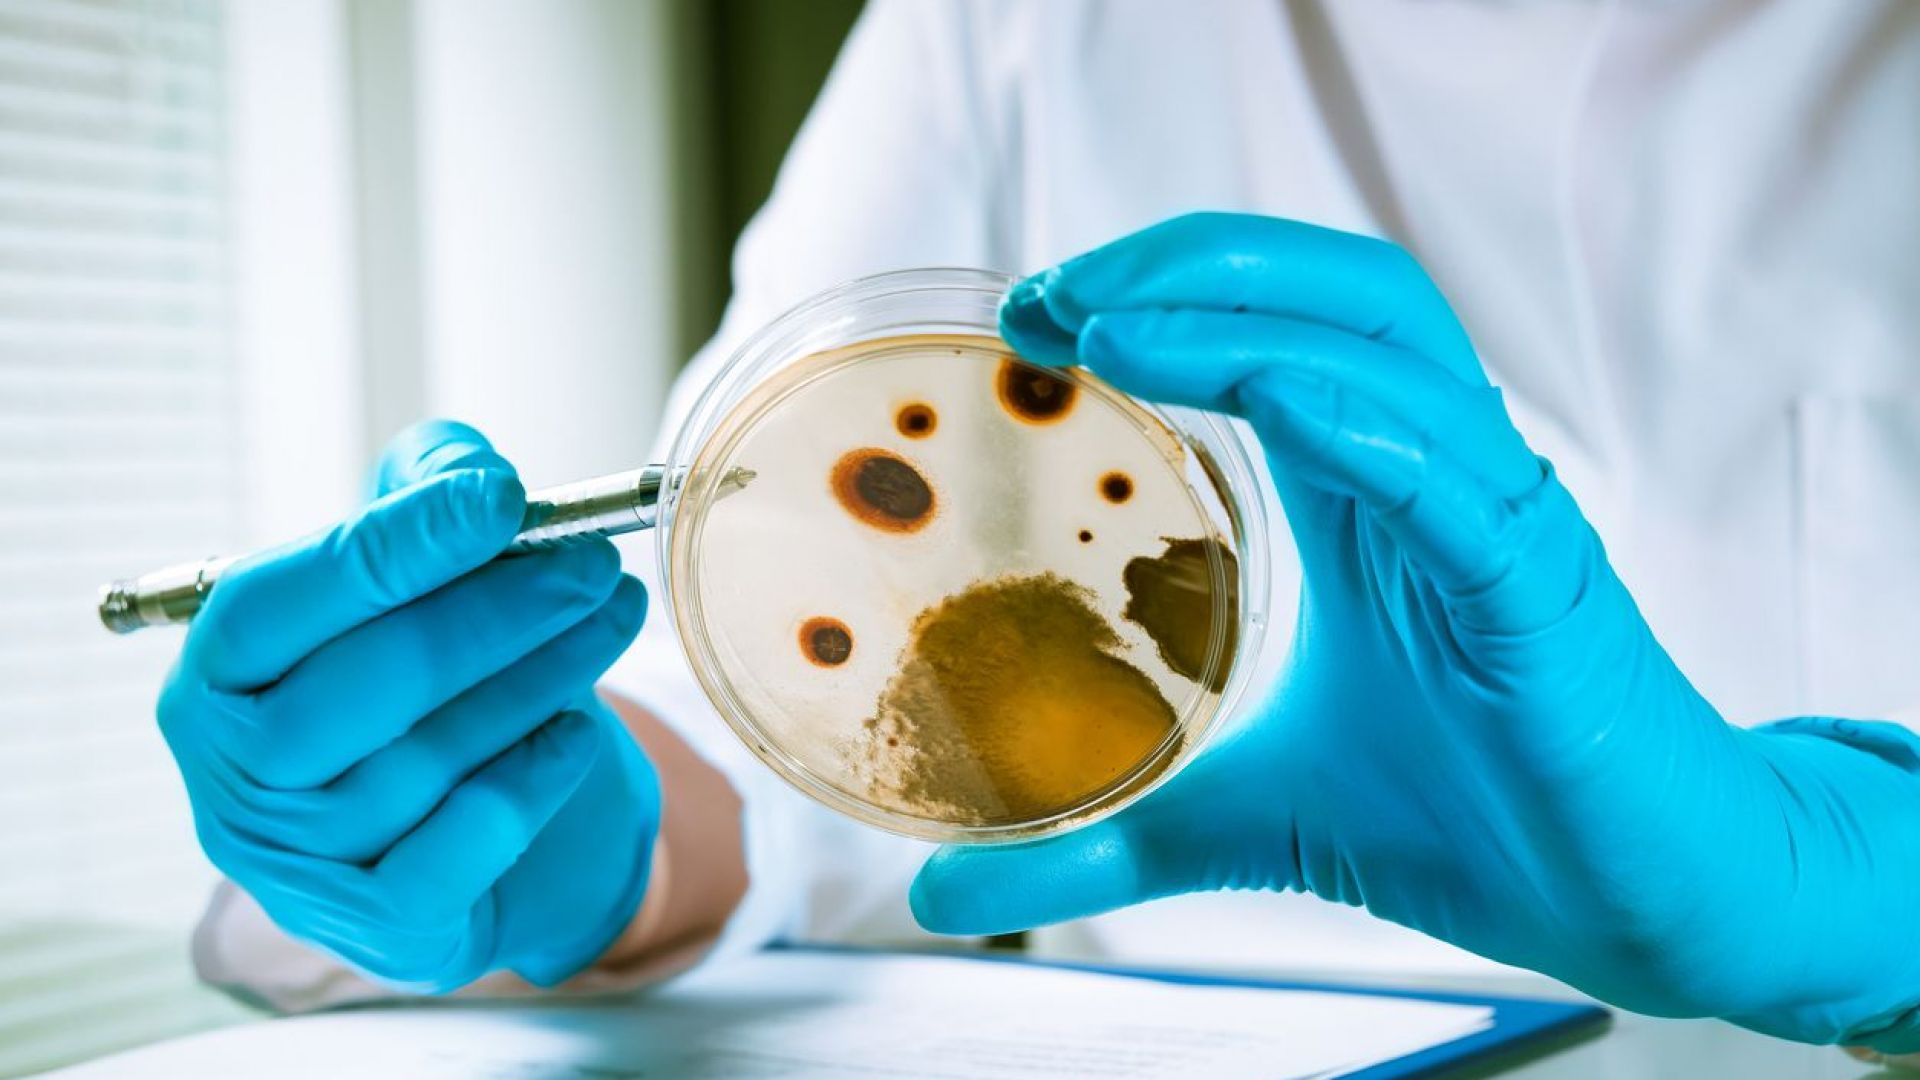
Епидемия от листериоза бактерията в свинското месо е установена

... пилешко къри; Centra Froodly Preet Burger Dinner; Supervalu и Centra Food To Go Mash Cototh; Aldi специално подбрани спагети Болонезе; Aldi вдъхновена кухня ирландска вила.
Епидемия Листериоза - Новини
Няма опасност от епидемия от листериоза в България В това
...... не е за подценяване, не е лек причинител, макар че е навсякъде около нас, птици, риби, животни, почви, но въпреки това тя крие своите рискове.
От Агенцията по храните уверяват че всички продукти които са
...... усложнения.По думите на д-р Баймакова бактерията не е за подценяване. Тя посочи, че не трябва да се консумират още непастьоризирани млека и меки сирена. /БНТ
Оказа се че няма опасност от епидемия от листериоза в
...... хоспитализация. Това разясни гл. ас. д-р Магдалена Баймакова, катедра "Инфекциозни болести", ВМА.Симптомите са температура, гадене, повръщане, диария, но при рисковите групи може да има усложнения.
Осем души са регистрирани с листериоза у нас Това каза
...... на [email protected] по всяко време на дежурния редактор!За реклама виж - https://petel.bg/advertising-rates.html-->-->-->-->рекламаКоментариКоментирай чрез FacebookЗа да пишете коментари, моля регистрирайте се за секунди ТУКНапиши коментарИме:Коментар:
Епидемията от листериоза в Испания се превърна в международна заплаха
...... имунна система. Най-често с нея може да се заразим чрез консумация на храни, които не са преминали предварителна термична обработка. По публикацията работи: Габриела Джекова
Епидемия от листериоза бактерията в свинското месо е установена
...... дойдохме направо в болницата”, каза Алехандро Херера. Здравното министерството там заяви, че проверява още 523 заподозрени случая. Годишно Испания се посещава от 80 млн. туристи.
Епидемия от листериоза бактерията в свинското месо е установена
...... да уврежда плода, за хора в по-напреднала възраст, за хора с хронични заболявания, хора с проблеми в имунитета", посочи държавният здравен инспектор д-р Ангел Кунчев.